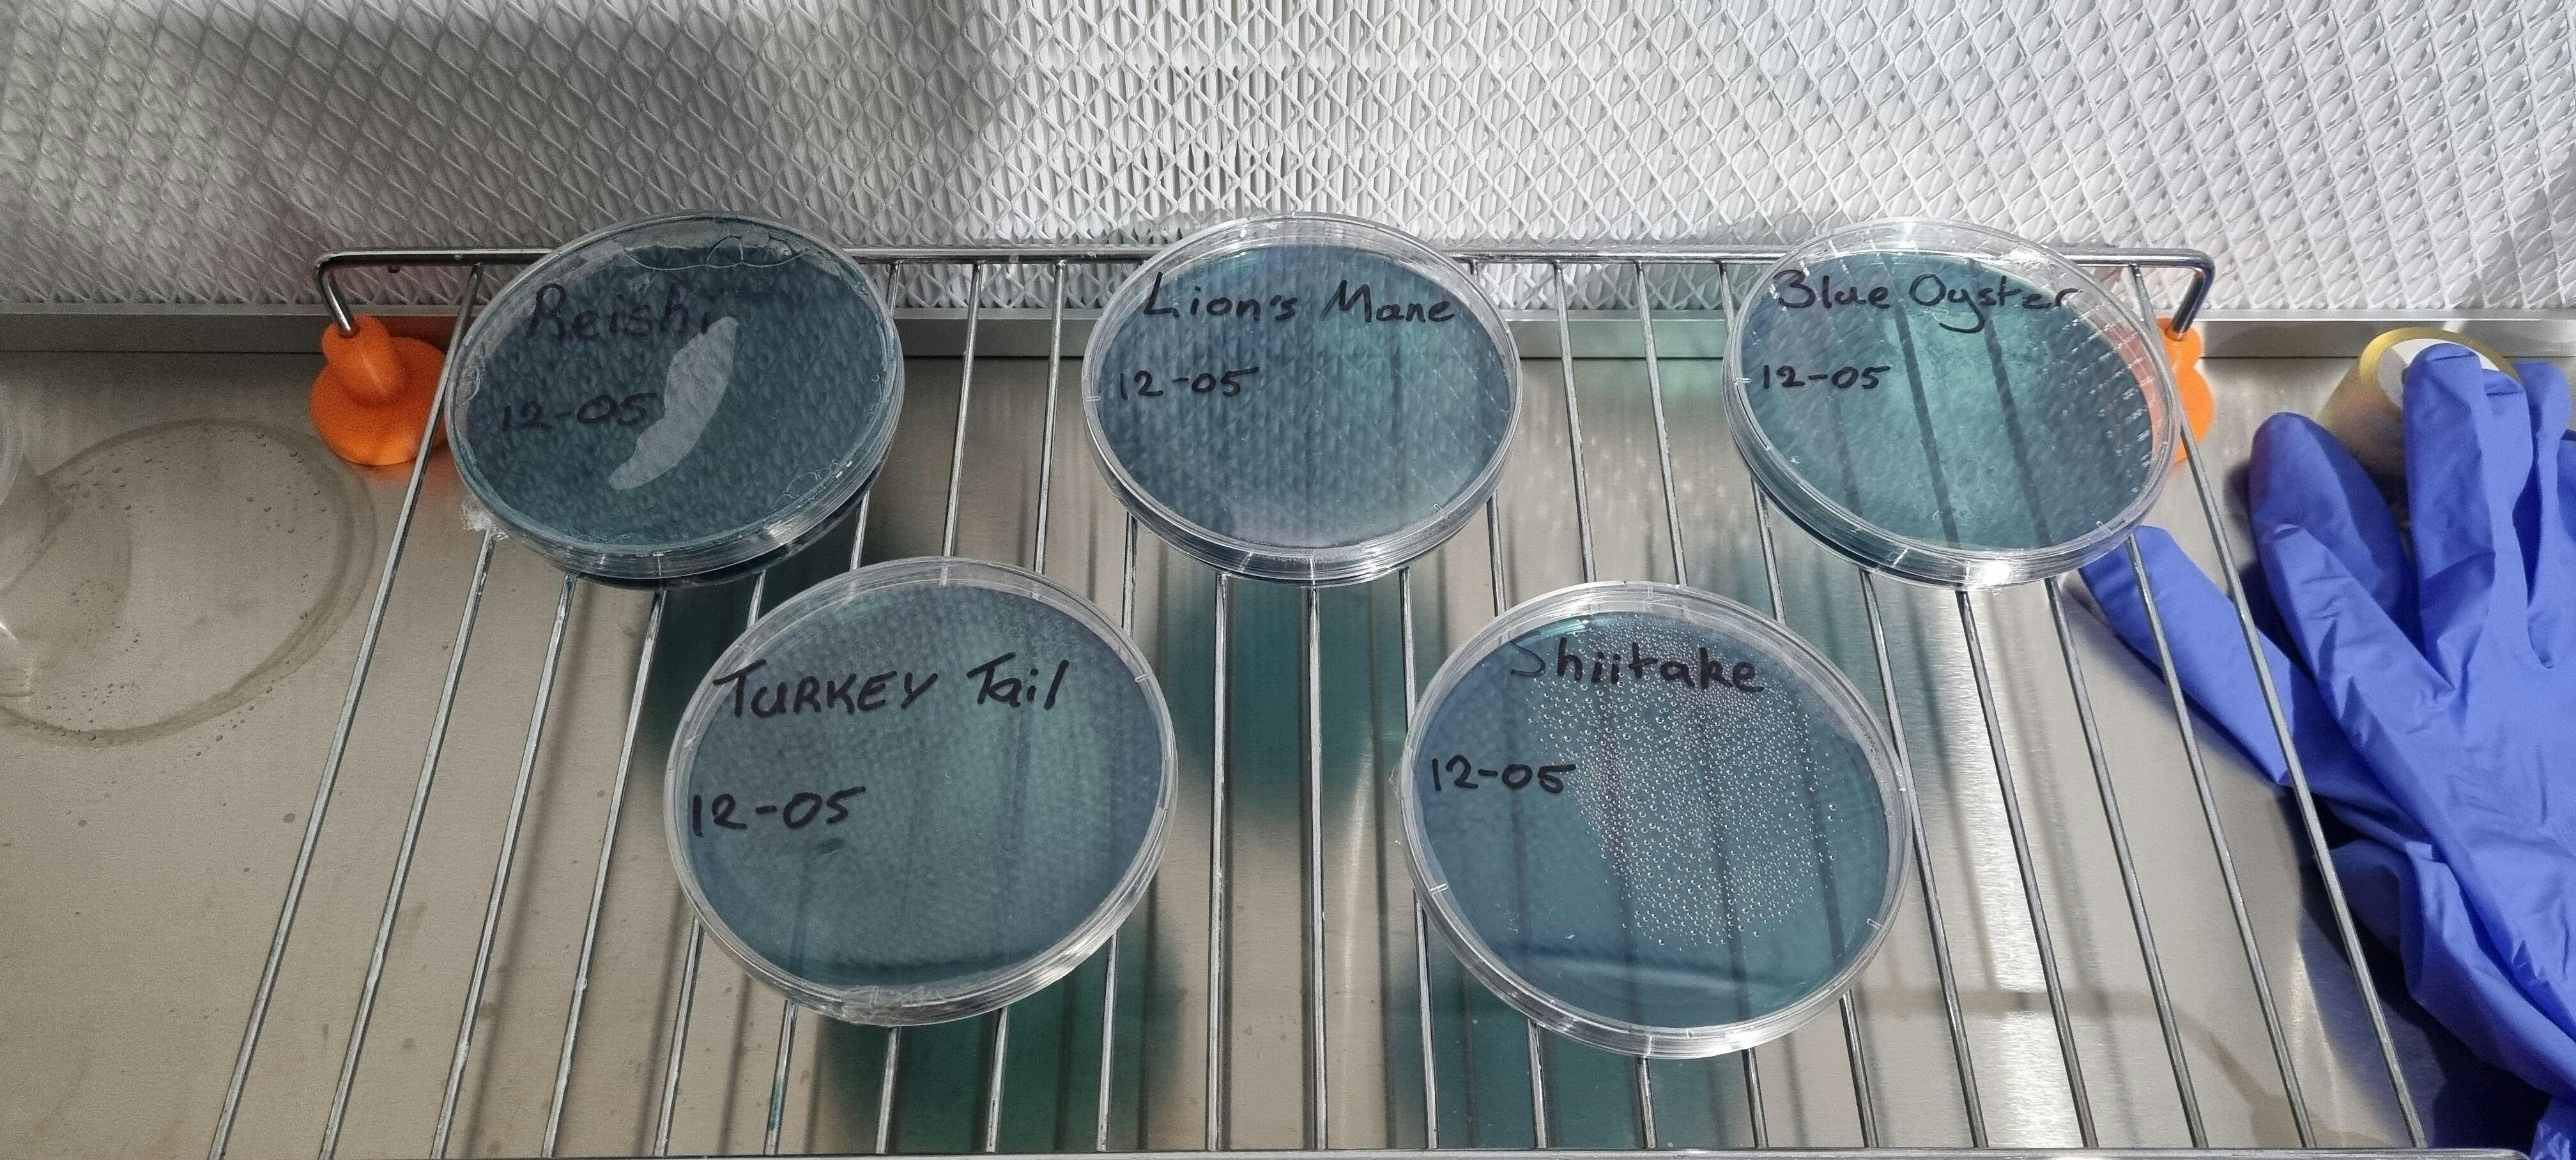

1175m x 575mm Hepa Laminar Flow Hood FFU H14 99.995% Filter
1175m x 575mm Hepa Laminar Flow Hood FFU H14 99.995% Filter
Couldn't load pickup availability
Please contact me for a shipping quote
Sample Can Be Viewed In Thornlie 6108
Experience Pure Air with Our Alu Coated Galvanized Case Filtration System
Introducing the future of indoor air management – our advanced filtration system, designed for efficiency and reliability. Wrapped in a sturdy Alu Coated Galvanized Case, this system is not just a piece of equipment; it's a promise of cleaner, healthier air for your environment.
Key Features:
- Powerful Fan Motor: Equipped with an AC 230V 50Hz motor, our system delivers a maximum wattage of 180W, ensuring an air volume of 1000m³/H at a speed of 0.45m/s. The Alu Impellers are engineered for optimal air distribution.
- Smart Fan Control: With a 3-step regulator, you can easily adjust the airflow. The standard air flow speed is maintained at 0.45m/s±20%, giving you precise control over your environment's air circulation.
- Secure Hepa Filter Installation: Our system features 4 Metal Locks to securely hold the Hepa Filter to the Hood, ensuring no air bypass and maximum filtration efficiency.
- Enhanced Pre-filtration: Each unit includes a G4 prefilter, which captures the larger particles, prolonging the life of the main H14 Hepa filter.
- Superior Hepa Filter: The included H14 Hepa filter boasts an exceptional 99.995% efficiency at 0.3um, supported by 4 brackets that firmly anchor it to the FFU case.
- Quiet Operation: With a noise rating of only 57dB±5dB at 1 meter from the filter face, our system operates whisper-quiet, ensuring a disturbance-free environment.
- Perfect Dimensions: The unit measures 1175x575x320mm, with the Hepa filter fitting neatly, making it an ideal choice for various spaces.
Elevate Your Air Quality Today!
1 Year Warranty On Electrical And Motor
Shipping Not Included
Share



Good price, good service, good Flow Hood!
Dave was quick to sort out a freight problem and courier related damage without question or hesitation. Communication was exceptional.
Unit works very well, and is well designed.
Highly recommended.
The FFU gives good flow.
Medium speed is adequate for the work Ive done. Overall a quiet solid unit!
Easy transaction. Great seller with good communication.
No problems